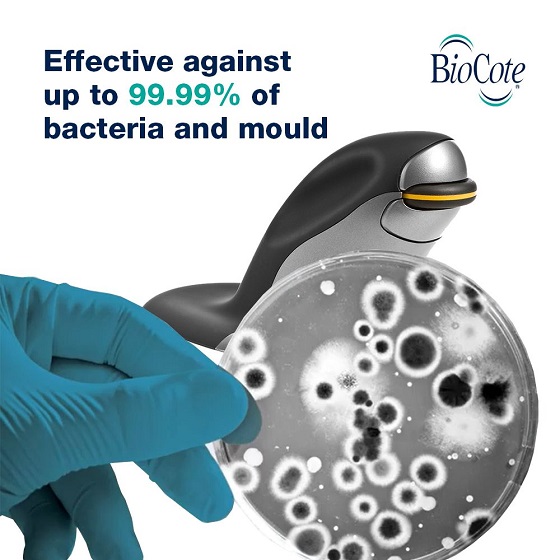

Penguin Ambidextrous Vertical Mouse Medium 3-in-1 2400 DPI
Kod: 100106080Produkty powiązane
Opis szczegółowy produktu
Mysz Penguin Mouse jest wyposażona w technologię antybakteryjną BioCote®, która hamuje rozwój bakterii, dzięki czemu idealnie nadaje się do współdzielonych przestrzeni roboczych i środowisk pracy o dużym zagęszczeniu.
Mysz Penguin Mouse jest dostępna w trzech rozmiarach i można ją wybrać, mierząc dłoń od pierwszego zgięcia nadgarstka do czubka środkowego palca.
Specyfikacja: przewodowa, bezprzewodowa i Bluetooth pionowa mysz komputerowa Penguin Ambidextrous MEDIUM oburęczna model 100106080.
Zalety produktu:
- dostępna w trzech rozmiarach, pasujących do różnych rozmiarów dłoni
- połączona technologia przewodowa, bezprzewodowa i Bluetooth
- pionowa konstrukcja zapewnia bardziej ergonomiczną pozycję dłoni
- regulowane ustawienia DPI (800, 1200, 1600 lub 2400) dla szybkiego i precyzyjnego przesuwania kursora
- precyzyjne kółko przewijania dla płynnej i precyzyjnej nawigacji po dokumentach
- klawisze miękkie o niskiej sile nacisku i pełnym skoku dla wygodnego pisania
- powierzchnia pokryta technologią antybakteryjną BioCote®, która redukuje bakterie nawet o 99,99%
Specyfikacja techniczna:
- dla rozmiaru dłoni: Medium
- połączenie: przewodowy, bezprzewodowy 2,4 GHz, Bluetooth
- technologia skanowania: optyczna
- zasilanie: wbudowany akumulator litowo-jonowy
- żywotność baterii: do dwóch tygodni
- pojemność baterii: 500mAh
- czas ładowania ok. 3 godziny
- rozdzielczość: 800/1200/1600/2400 DPI
- instalacja: Plug & Play
- liczba przycisków myszy: 3
- całkowita liczba przycisków: 5
- zastosowanie: oburęczne
- kolorystyka: czarna
- wymiary: 85,7 x 157,2 x 109,5 mm
- obsługiwany system operacyjny: Windows 98/ME/XP/2000/Vista/7/8/10, Mac: OS X i nowsze
- zawartość opakowania: mysz bezprzewodowa, odbiornik USB, kabel ładujący
Tabela rozmiarów dłoni:

Parametry dodatkowe
| Kategoria: | Myszy |
|---|---|
| Gwarancja: | 2 lata |
| EAN: | 5060009942287 |
| Połączenie: | Przewodowy + Bluetooth + Bezprzewodowy |
| Typ: | Biuro |
| Zasilacz: | Wbudowana bateria |
| Kompabilita: | MacOS, Windows 7, Windows 8, Windows 10, Windows 11, Windows XP, Windows Vista |
| Liczba przycisków: | 5 |
| Funkcje przycisków: | Zmiana DPI, Prawo-Lewo |
| Technologia: | Optyczny |
| Rozmiar: | Medium |
| Nieruchomości: | Podwójne whammy, Gumowany, Odłączany kabel, Podpórka pod nadgarstki, Krawędź podpórki pod dłoń |
| Czułość DPI: | 2400 |
| Kolor: | Czarny |
| Długość kabla: | 120cm |
| Waga: | 230g |
| Info: | Proven antimicrobial protection |
Video
Video
Bądź pierwszą osobą, która napisze opinię do tego produktu.
Opinie
Bądź pierwszą osobą, która napisze opinię do tego produktu.
